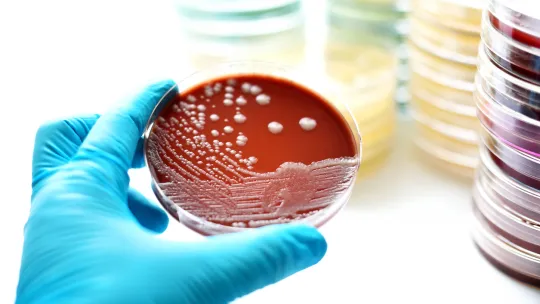
toxiinfección-alimentaria.jpg toxiinfección-alimentaria.jpg

Nuestros Expertos VIU
Artículos de actualidad sobre nuestras principales áreas de conocimiento

14 de Noviembre de 2017
El Día Mundial de la Sonrisa: descubre los beneficios de sonreír
Ciencias de la Salud
10 de Noviembre de 2017
La traducción audiovisual. Breve contextualización de la especialidad
Artes y Humanidades
9 de Noviembre de 2017
Procrastinar mal hábito para el aprendizaje y el rendimiento académico
Educación
9 de Noviembre de 2017
¿Conocemos los derechos de nuestros mayores en el ámbito sanitario?
Ciencias de la Salud
9 de Noviembre de 2017
¿Infección o intoxicación? Conociendo la toxiinfección alimentaria
Ciencias de la SaludArtículos destacados
-
¿En qué consiste la IA generativa?¿Qué es la IAG y para qué sirve? ¿En qué se diferencia de la inteligencia artificial tradicional? ¿Qué ejemplos destacan en el campo de la IA generativa?
-
Gestión de proyectos: 3 tendencias que plantean nuevos retos y oportunidadesEl campo de la gestión de proyectos se caracteriza por ser dinámico y estar en una evolución constante. Cada año, surgen nuevas metodologías, tecnologías y enfoques con los que hacer frente a las nuevas y exigentes demandas que surgen en el entorno empresarial. Por ello, una de las responsabilidades prioritarias de un Project Manager es estar actualizado y anticiparse a todos estos cambios en el sector. Solo de este modo es posible superar los retos y aprovechar las oportunidades que nacen constantemente en el sector empresarial.
-
Las claves de la ciencia de datos¿Qué es la ciencia de datos y para qué sirve? ¿Por qué es importante y cómo se aplica? Son algunas de las dudas habituales que formulan los interesados en la ciencia de datos.
-
La psicología y su relación con otras ramas de la cienciaLa psicología es la disciplina que se ocupa del estudio de los procesos mentales. Su objetivo es comprender los mecanismos cognitivos y emocionales que subyacen en la conducta humana. Aunque ya los antiguos griegos exploraron la complejidad de nuestra psique, no fue hasta el siglo XIX cuando la psicología comenzó a establecerse como ciencia. Pero ¿cuál es su lugar exacto entre las diferentes ramas de la ciencia?
-
Todo lo que necesitas saber sobre la energía cinéticaAntes de comentar la definición de energía cinética, consideramos esencial subrayar algunos aspectos. Hay distintas formas de energía (la eléctrica, la mecánica o el calor, por citar algunos ejemplos), pero todas se clasifican en dos grandes grupos.
El primero es la energía potencial, que es la que un cuerpo tiene por estar dentro de un campo de fuerzas. Al mismo tiempo, es también la que tiene un sistema gracias a la estructura de su campo de fuerzas interno. El segundo grupo es la energía cinética, que ahora definimos. -
Proceso de atención de enfermería: concepto y etapasLa atención de enfermería resulta fundamental en la sociedad actual para aportar una atención de calidad a los pacientes. Esta profesión se ha convertido en una de las más demandadas y reconocidas en nuestra sociedad, lo que impulsa al Ministerio de Sanidad a potenciarla. Dentro de ella, el PAE o Proceso de Atención de Enfermería es la piedra angular de toda la actuación sanitaria.
-
Teorías del universo: origen y evoluciónA la hora de estudiar el universo, el ser humano ha desarrollado diferentes teorías del universo que explicasen cómo funciona y cuál era su origen. La ciencia y la astronomía modernas nos han permitido profundizar aún más en el estudio del cosmos y, actualmente, podemos tener una idea mucho más certera de la naturaleza del universo y de cuál fue su origen y hacia dónde va encaminada su evolución.










